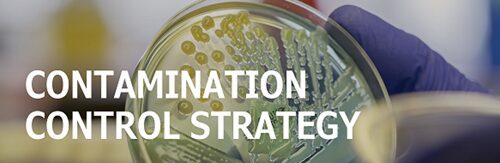

Unfortunately in much of the United States we are having unbelievable weather issues. With storms and scorching heat, one thing is for sure; an increased level of bugs and insects are causing additional problems. Whether it is just annoyance or a real health problem, there are ways to alleviate some of the harshness.
OFCO introduced a new product this year, our Model “PS” Suction Strainer for use in portable insect control misting equipment. These were manufactured especially for use in the insect control industry. If you are in the insect control industry, see how we can help you keep your equipment effective. Our “PS” Strainers for insect control equipment produce a finer, more effective mist.
Click here to learn more
Last time, in Part 1 (the Introduction), we started with the topic of sizing a filter to an application. To get the best performance out of your hydraulic system, it’s essential to have proper filtration. We continue to emphasize, “if the filtration breaks down, the system will break down.” The first item on your list to consider is the pump’s flow rate. Knowing the flow rate tells you how much surface area is needed to perform efficiently. It is common knowledge that no matter what the flow is, there will be a pressure drop through the filter. The question to remember is how much screen area one needs to keep the pressure drop minimal and maintain smooth operation. Next time we will discuss pipe size.

1. The pressure relief valve is an important component which is required for every displacement pump.
True ______ False ______
The correct answer is True. The valve is connected to the outlet of the pump. Its main function is to release the oil back to the tank when the pressure exceeds the pre-set values.
2. How many types of actuators are present in hydraulic systems?
A. One B. Two C. Three D. Four
The correct answer is B. Actuators produce work. There are two types of actuators, linear and rotary. The linear actuator is called the cylinder and a rotary actuator is called the motor. The force developed is given by the product of the pressure of oil and area of the piston.

3. Which type of system uses ‘oil under pressure’ means for power transmission?
A. Fluid power system
B. Hydraulic system
C. Pneumatic system
D. Stepper motors
The correct answer is B. Fluid power system is a power transmission in which the transmission takes place by means of “oil under pressure” or “compressed air.” If “oil under pressure” is used in the system for power transmission then the system is called a hydraulic system. If “compressed air” is used in the system for power transmission, then the system is called a pneumatic system.
Keeping contamination under control is a top priority when operating a hydraulic system. In the design phase, start by figuring out your target levels for fluid cleanliness, and then take the steps needed to hit and keep those targets. But don’t just set it and forget it. It’s crucial to regularly check if you’re staying on track. You’ll want to monitor ISO levels to ensure you’re meeting the guidelines for fluid cleanliness. It’s hard to accomplish that without particle counters. And make sure your design includes sample ports so you can regularly check fluid samples—it’s like a regular health check-up for your system.
Whether you’re simply trying to prevent big chunks from causing havoc, or you’re dealing with micro-filtration or ultra-filtration to protect a high-stakes operation, careful planning is a must. Think of it this way: You wouldn’t build a house without a blueprint, right? The same goes for your systems. And after all that meticulous design work, you’ve got the responsibility to keep it running smoothly. It’s like maintaining a car—skip regular service, and you’re headed for a breakdown. The cleanliness of your fluid should be at the top of your list. Fluid is the lifeblood of your system. Respect it. Learn about filters, the equipment, the core principles, fluid properties, testing, and standards. Everyone gets that education is a game-changer. So, bet on your future! Invest in yourself!
OFCO has recently unleashed its new spin-on filters (SP Series). We realize that spin-on filters are a staple product and used in many applications as an excellent fluid contamination control device. However, they can also be used as a very efficient tank breather, preventing airborne contamination from entering the system. What many do not realize, with the optional breather adapter, the spin-on filter can be turned into a tank breather. There are a few advantages over the smaller tank breathers, too.